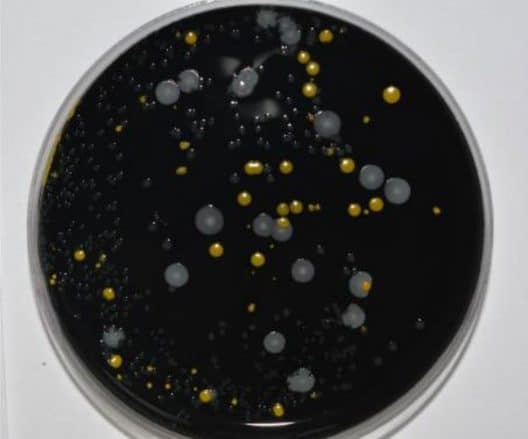

TVVL Magazine
TVVL Magazine
Installaties Duitsland
Normalistatie installatiesector
Evenementen
toekomst
berekening
constructie
ontwerp
Nieuwbouw
ISSO
regelgeving
Legionella
Waterleiding
drinkwater
kwaliteit
sanitaire technieken
veiligheid
energie-efficientie
Duurzaamheid circulariteit
gezondheid
licht
Duurzaamheid
Waterinstallaties
TVVL Magazine
ventilatie
Gezonde gebouwen